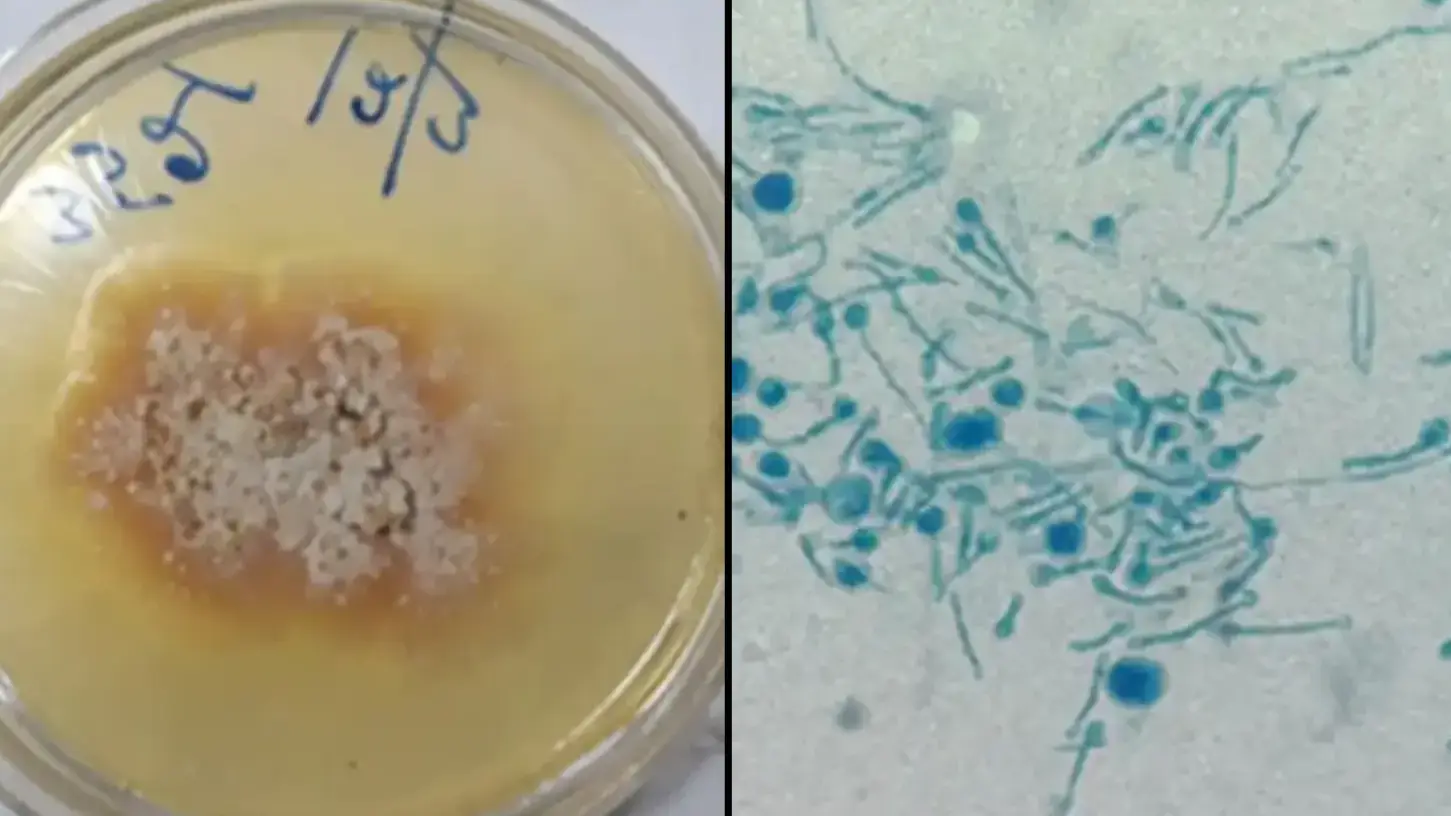
Man becomes first known person to be infected by killer plant fungus
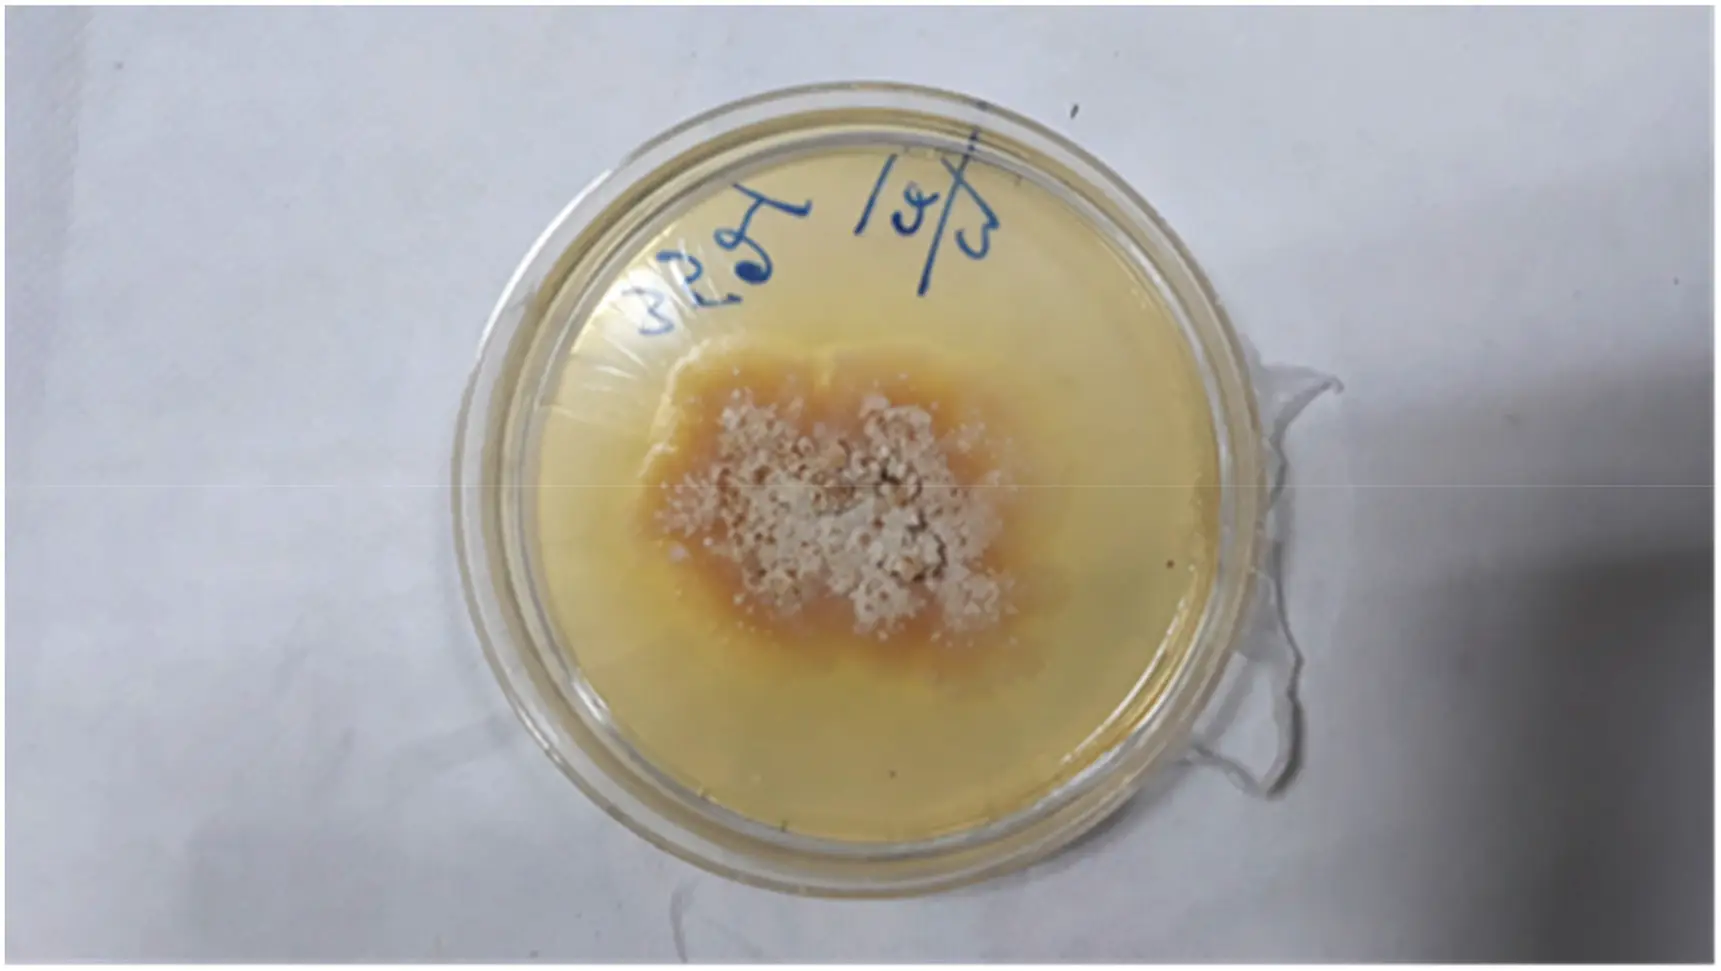

A 61-year-old man has become the first-ever recorded human to be infected from a killer plant fungus after it jumped from plant to person.
An Indian plant mycologist caught the fungal disease after suffering from flu-like symptoms for months.
He also struggled with swallowing for three months before doctors carried out scans that showed a huge abscess in his windpipe.
Doctors drained the abscess and sent samples of the infection to the lab for testing, where analysis indicated the man had been infected by the chondrostereum purpureum virus.
Advert
This is the first case of the fungus jumping from plant to a human. The fungus typically causes silver leaf disease in plants.
It spreads by airborne spores and leaves plant foliage an odd metallic colour before slowly killing them off.
The man was believed to have been infected while carrying out research as a mycologist.
Plant mycologists work directly with moulds, yeast and mushrooms.
The man, who was not named in the journal Medical Mycology Case Reports, had been working with mushrooms, plant fungi and decaying material 'for a long time', the doctors who treated him claimed.
Experts have warned this first-ever case 'raises serious questions' because it proves the infection can affect both 'healthy as well as immunocompromised individuals'.
The alarming medical incident bears a striking similarity to HBO's smash-hit show The Last of Us.
The show opened with a chilling scene explaining just how the cordyceps fungus, which turns people into the infected horrors we see in the show, could develop.
In a scene set years before the events of the show, Dr Neuman (John Hannah) warns how the cordyceps virus can control the creatures it infects.
But could this actually happen in real life?
That's something scientists have been looking into and Matt Kasson, Associate Professor of Mycology at West Virginia University, has said it already exists in some form.

He told Inside Edition that The Last of Us was already a reality 'in the insect world', noting that 'ants have a fungus that does this' and that cicadas also fell prey to fungus too.
This was mentioned in that opening scene of The Last of Us, with Dr Neuman explaining that the idea that a fungus could take over a living thing was already happening.
So, could such a thing actually shift from tormenting insects and to hijacking humans, ushering us into a post-apocalypse on the scale of The Last of Us that upends our entire way of life?
Well, it hasn't hijacked anyone just yet... but this is an alarming step forward.
Topics: Health, Weird, TV and Film